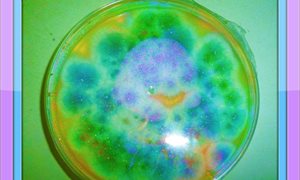

De algemeen voorkomende schimmel Aspergillus fumigatus voelt zich erg op zijn gemak in composthopen waar hij bijdraagt aan de afbraak van natuurlijke materialen. Om te kunnen groeien in de natuur moet de schimmel zich aanpassen aan de soms snel veranderende omstandigheden. Onderzoekers van Schimmelexpertise Centrum Radboudumc/CWZ en Wageningen Universiteit hebben vastgesteld dat de Aspergillus schimmel zich niet alleen gemakkelijk aanpast aan veranderende omstandigheden in de natuur, maar dat ook kan in de longen van patiënten met een verminderde afweer.
Wel of niet behandelen?
Het onderzoek van de Nijmeegse en Wageningse onderzoekers wijst erop dat elke verandering een prikkel kan zijn voor de schimmel om zich aan te passen. Dat geldt bijvoorbeeld niet alleen voor het starten van een behandeling, maar ook de vervanging van het ene antischimmelmiddel door een ander en óok voor het stoppen van de behandeling. De wetenschap dat élke verandering in het omringende milieu tot veranderingen in de schimmel kan leiden, levert een moeilijk dilemma op voor artsen. Een behandeling met medicijnen kan tot schimmelresistentie leiden, maar niet behandelen of zelfs stoppen met behandelen stelt de schimmel in staat om zich beter te nestelen in de longen. In beide gevallen kan een situatie ontstaan waarbij de patiënt niet meer schimmelvrij is te krijgen. Dit onderzoek heeft vooral gevolgen voor longpatiënten die de Aspergillus schimmel langere tijd bij zich kunnen dragen, zoals patiënten met COPD of taaislijmziekte (cystische fibrose). Aanpassing van de huidige behandelingsrichtlijnen zal nodig zijn.
Beter begrip
Meer onderzoek is nodig om aanpassing van de schimmel in de long beter te begrijpen en te bepalen hoe aanpassing van de schimmel in de patiënt het beste is te voorkomen. Daarom werken schimmelonderzoekers van het Schimmelexpertise Centrum Radboudumc/CWZ en WU intensief samen. Ze willen nu het aanpassingsvermogen van de Aspergillus schimmel en de resistentievorming beter proberen te begrijpen, zowel in de patiënt als in de natuurlijke omgeving.
-
Publicatie in The Lancet Infectious Diseases - In-host adaptation and acquired triazole resistance in Aspergillus fumigatus: a dilemma for clinical management. Verweij PE, Zhang J, Debets AJ, Meis JF, van de Veerdonk FL, Schoustra SE, Zwaan BJ, Melchers WJ
-
Meer weten over deze onderwerpen? Klik dan via onderstaande buttons door naar meer nieuws.





